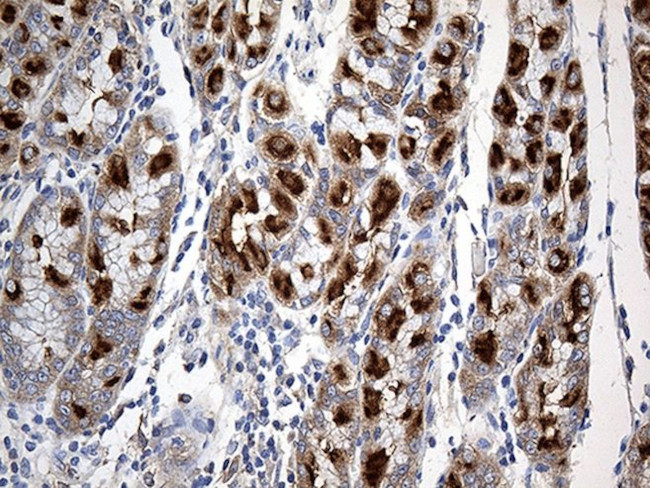
CHP1 Antibody in Immunohistochemistry (Paraffin) (IHC (P))
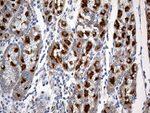
CHP1 Antibody in Immunohistochemistry (Paraffin) (IHC (P))
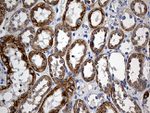
CHP1 Antibody in Immunohistochemistry (Paraffin) (IHC (P))

Search
OriGene
CHP1 Monoclonal Antibody (OTI3H3), TrueMAB™
{{$productOrderCtrl.translations['antibody.pdp.commerceCard.promotion.promotions']}}
{{$productOrderCtrl.translations['antibody.pdp.commerceCard.promotion.viewpromo']}}
{{$productOrderCtrl.translations['antibody.pdp.commerceCard.promotion.promocode']}}: {{promo.promoCode}} {{promo.promoTitle}} {{promo.promoDescription}}. {{$productOrderCtrl.translations['antibody.pdp.commerceCard.promotion.learnmore']}}
产品信息
TA810154
种属反应
宿主/亚型
分类
类型
克隆号
抗原
偶联物
形式
浓度
纯化类型
保存液
内含物
保存条件
运输条件
靶标信息
Regulates centrosome duplication, probably by inhibiting the kinase activity of ROCK2. Proposed to act as co-chaperone for HSP90. May play a role in the regulation of NOD1 via a HSP90 chaperone complex. In vitro, has intrinsic chaperone activity. This function may be achieved by inhibiting association of ROCK2 with NPM1. Involved in stress response. Prevents tumorigenesis.
仅用于科研。不用于诊断过程。未经明确授权不得转售。
篇参考文献 (0)
生物信息学
蛋白别名: calcineurin B homolog; Calcineurin B homologous protein 1; Calcineurin B-like protein; calcineurin homologous protein; calcineurin-like EF hand protein 1; calcineurin-like EF-hand protein 1; calcium binding protein P22; Calcium-binding protein CHP; Calcium-binding protein p22; EF-hand calcium-binding domain-containing protein p22; SLC9A1 binding protein
基因别名: CHP; CHP1; p22; p24; Sid470p; SLC9A1BP
UniProt ID: (Human) Q99653
Entrez Gene ID: (Human) 11261